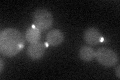
YNL298W
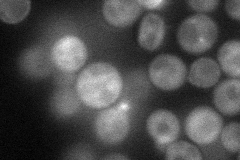
YNL298W
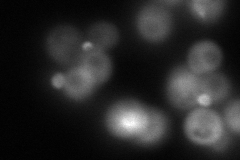
YNL298W
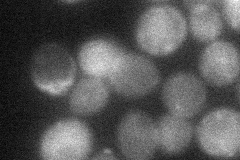
YNL298W
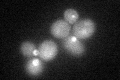
YNL298W

View description
Cdc42p-activated signal transducing kinase of the PAK (p21-activated kinase) family, which also includes Ste20p and Skm1p; involved in septin ring assembly, vacuole inheritance, and cytokinesis; phosphorylates septins Cdc3p and Cdc10p
Localization:
Intensity:
Fold change:
Significance:
-
C’ GFP library in SD
bud neck -
N' NOP1pr-GFP in SD
cytosol,bud49.9933 -
N' TEF2pr-mCherry in SD
cytosol,bud21.7648 -
N' NATIVEpr-GFP in SD

bud26.9648 -
N' TEF2pr-VC and Cyto-VN in SD
bud37.067 -
C’ GFP library in SD+DTT
bud neck23.840.89No -
C’ GFP library in SD+H2O2

cytosolN/AN/ANo -
C’ GFP library in Starvation Media

cytosol18.350.68No -
C’ GFP library on the background of Pup2-DaMP

bud neck -
C’ GFP library on the background of CCT mutant

bud neck24.73010.923894No
